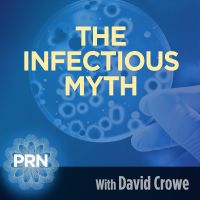

More
Religion & Spirituality
Education
Arts and Design
Health
Fashion & Beauty
Government & Organizations
Kids & family
Music
News & Politics
Science & Medicine
Society & Culture
Sports & Recreation
TV & Film
Technology
Philosophy
Storytelling
Horror and Paranomal
True Crime
Leisure
Travel
Fiction
Crypto
Marketing
History

.png)
Comedy
Arts
Games & Hobbies
Business
Motivation